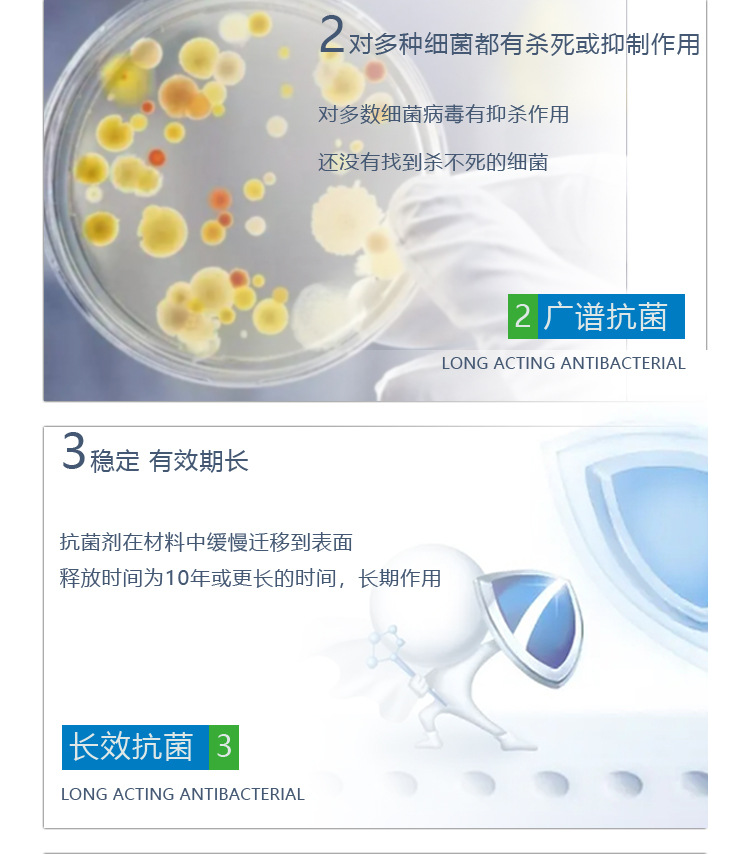
undefined
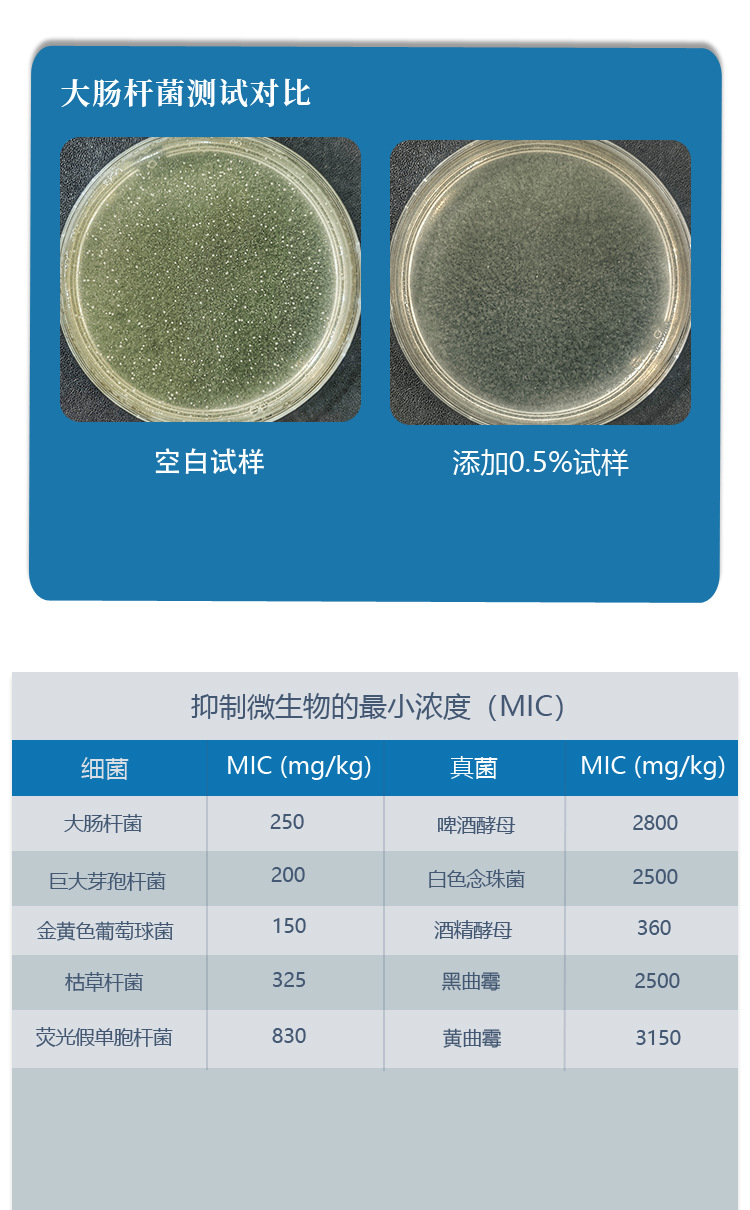
undefined

http://www.gdfm360.com
276533448@qq.com
广东科普茵生物科技有限公司为您提供抗菌剂、防霉剂、防霉抗菌剂,应用于工业防霉剂、塑料抗菌剂和板材防霉抗菌净醛剂等为产品护航,欢迎咨询。
广东科普茵生物科技有限公司
安全 高效 长久抗菌 提供防霉抗菌净醛解决方案及产品
ISO9001 国际质量体系认证
2023-09-26
科普茵生物专注防霉抗菌净醛产品研发;为板材、密封材料、橡塑、涂料、纺织、日化、鞋服、皮革、胶水等行业领域,提供成熟防霉抗菌净醛解决方案及产品。

发布时间:
热门搜索
家里床柜发霉了怎么办?该如何防潮、防霉呢?
耐高温塑料抗菌剂 如何选择防霉抗菌剂?
防霉剂的作用原理是怎样的?海运怎样防霉?
抗菌剂有哪些标准? 抗菌剂的种类有哪些?
怎样选择防霉剂? 怎样判断防霉剂好与坏?
成品鞋子应该怎样防霉? 家具应该怎样防霉?
抗菌剂的定义,抗菌塑料如何选择抗菌剂?
家居怎样彻底除霉? 抗菌剂和防霉剂的区别?
你是不是还想搜
科普茵产品 关于科普茵KEPUYIN 科普茵动态
防霉喷剂 皮革防霉剂 皮革反霜怎么办?
塑料抗菌剂 抗菌剂有哪些 抗菌剂百科
硅酮胶能防霉吗 硅酮胶、MS胶、玻璃胶防霉剂
纳米抗菌剂 发泡材料抗菌剂
塑料色母专用抗菌剂 注塑母粒抗菌剂
科普茵防霉方案 服务客户成功案例
如何联系科普茵防霉抗菌公司
纺织抗菌剂 AEM5700抗菌剂
气相防霉纸 气相防霉片 成品防霉必备
塑料防霉剂 PU/PVC/TPU/TPE/EVA/TPR、
聚氨酯、丙烯酸树脂、橡胶、硅橡胶专用防霉剂
最新动态,这里有你想要的防霉抗菌知识
塑胶抗菌剂 透明PS超高性价比抗菌原粉塑料ABS玩具PP抗菌防霉剂
科普茵生物专注防霉抗菌净醛产品研发;为板材、密封材料、橡塑、涂料、纺织、日化、鞋服、皮革、胶水等行业领域,提供成熟防霉抗菌净醛解决方案及产品。
纺织面料抗菌 银离子抗菌剂不会促进纤维的老化降解
银离子抗菌剂中有效物质是正三价的银离子,银能起到催化活性中心的作用,可以使周围空间产生原子氧,而原子氧可杀菌,银离子可强烈地吸引细菌肌体中的巯基,破坏细胞合成酶的活性,细菌就会被杀死
纺织防霉抗菌剂 广谱型液体防霉剂易溶于水性溶剂
纺织防霉抗菌剂是广谱型液体防霉剂,采用的原料为日化级原料,其作用机理是在有氧和无氧氛围下通过不同化学反应机理而起杀菌作用。在有氧氛围下,催化氧化半胱氨基酸为胱氨酸残基。
首页
上一页
1
2
3
4
5
...
448
下一页